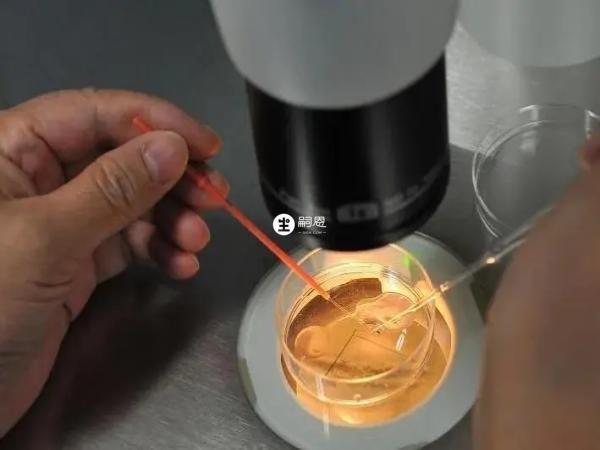
胚胎質量不好會導致鮮胚移植失敗

摘要
第三代試管相比於第二代和第一代來說,成功率要高出不少,但也無法保證百分百成功,具體的成功率還與患者年齡、身體情況、醫院操作水平等有關,不過三代試管能夠在發育的胚胎中活檢細胞,通過對染色體檢查,明確胚胎是否攜帶遺傳性疾病或染色體異常,對於高齡女性來說,三代試管可以顯著提升成功率。導致移植兩個鮮胚都著床失敗了的原因有很多,如夫妻雙方心理素質低下、後期孕酮補充不足、孕婦的身體條件不好以及子宮腔環境差等等。相信很多皆準試管嬰兒進行助孕的夫妻應該也知道,在實幹移植的時候,醫生一般都會利用兩個優質鮮胚進行移植,以提高試管試管嬰兒的成功。當然對於一些不太幸運的女性來說,在移植後都著床失敗了。

為了避免做試管嬰兒移植失敗,在選擇鮮胚移植前,往往會有人選擇同時移植兩個鮮胚,但即使是選擇同時移植兩個鮮胚,也有失敗的可能,很多人對此不解,不知道試管同時移植兩個鮮胚最後卻失敗的原因,這裡就給大家規納出試管移植兩個鮮胚都失敗的主要原因:
胚胎的染色體數目或結構異常,會導致移植後鮮胚死亡進而著床失敗,即使是成功著床之後也會出現流產的情況。
在以往的試管移植失敗案例中發現,導致試管鮮胚移植失敗的主要原因在於胚胎質量太差,而胚胎質量是由男女雙方的精子和卵子決定的。
子宮內膜厚度和激素水平達不到標準,胚胎著床的成功率就很低,如果子宮內部發生病變,也會導致鮮胚著床失敗。
做試管嬰兒移植前,如果女方心理素質比較低,並且在移植過程中過於的焦躁和不安,這些都會影響到鮮胚移植成功率。
若反覆失敗,但又無法明確失敗原因,患者可以到免疫專科醫院檢查免疫方面的問題,免疫異常也會導致移植失敗。
試管鮮胚不易著床可能是由於鮮胚剛經過了促排卵治療,這個時候女性身體內的激素水平相對較高並且不穩定,如果選擇在這個時候移植,會導致女性在身體激素不穩定或紊亂的情況下,就會影響到鮮胚移植後的成功率。

鮮胚移植後的成功率受到很多方面的影響,為了避免移植後失敗,女性一定要在日常做好一些事項,避免做鮮胚移植後失敗,在移植後需要注意以下情況:
事實證明,年齡稍大的女性,卵子質量也會變差,胚胎出現染色體異常的概率更高。如果患者年齡較大,這種情況依靠技術篩查染色體問題,選擇優質胚胎進行移植,可以提高胚胎移植的成功率。
移植後不要吃一些辛辣的食物,這類食物對腸胃有一定刺激,如果不注意,可能會發生腸炎,如果一直拉肚子,對胚胎著床有一定影響。

移植後應該儘可能躺在床上休息三天,仰臥使血液更容易流向子宮內膜,也更有利於胚胎的著床。
最重要的一點是保持心態平衡,著床過程中,如果過於緊張或擔心,會影響胚胎著床,所以要保持樂觀的心態。
不論是試管嬰兒還是懷孕期間,大家都存在不少的疑問,因為很多人不僅第一次做試管同樣也是第一次懷孕,因此下面就將當前網路上熱門的有關生育的疑問收集了起來,並一一為大家解答其中緣由:
1、第三代試管成功率高與胚胎染色體篩查有關